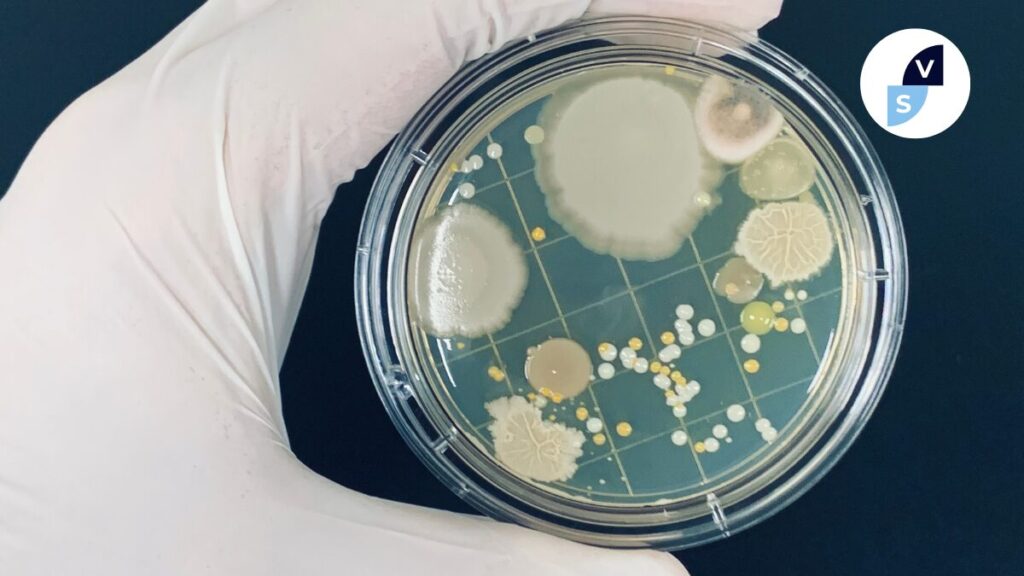

Nel 2050 l’antibiotico resistenza come la prima causa di morte con circa 8 milioni e 220 mila vittime. Intanto è stato creato l’Osservatorio nazionale sui risarcimenti derivanti da malpractice sanitarie, l’Osm, uno strumento che analizzerà i bilanci delle aziende sanitarie e ospedaliere con l’obiettivo di fornire indicazioni strategiche per la riduzione della spesa resistenza microbica
«La resistenza microbica impatta negativamente sulla sanità pubblica. Costa, secondo fonti European Ambrosetti, ogni anno 2,4 miliardi di cui il 60 per cento è da attribuire al costo delle complicanze mediche. È una battaglia che si vince non solo con la ricerca di nuovi antibiotici ma è indispensabile la collaborazione dei cittadini che devono essere istruiti a un uso corretto dei farmaci e imparare quei comportamenti che determino la riduzione dei super batteri. La lotta all’antibiotico resistenza può fare guadagnare all’Italia ogni anno circa 1,5 miliardi di euro. In termini di mortalità, le proiezioni sul prossimo futuro indicano nel 2050 l’antibiotico resistenza come la prima causa di morte con circa 8 milioni e 220 mila vittime». Così Massimo Andreoni, direttore scientifico della Società italiana di malattie infettive e tropicali (Simit) e professore emerito di Malattie infettive all’Università degli Studi di Tor Vergata, alla vigilia dello spettacolo ‘As it was – Le ultime ore del dottor Fulop Semmelweiss’, in scena domani alle 20 al teatro Sant’Afra di Brescia con il patrocinio della Regione Lombardia, della Regione Campania, del Comune di Brescia e della Simit.
La nascita dell’Osservatorio sui risarcimenti da malpractice resistenza microbica
«La spesa sanitaria italiana è gravata sempre più dagli effetti nefasti dell’antibiotico-resistenza e dal dilagare delle infezioni correlate all’assistenza, che determinano costi esorbitanti legati ai risarcimenti dovuti ai pazienti e alle degenze aggiuntive. Non esiste un big data che agglomeri questi numeri con la necessaria puntualità e per questo abbiamo deciso di dar vita all’Osservatorio nazionale sui risarcimenti derivanti da malpractice sanitarie, l’Osm, uno strumento che analizzerà i bilanci delle aziende sanitarie e ospedaliere con l’obiettivo di fornire indicazioni strategiche per la riduzione della spesa». A sottolinearlo è Raffaele Di Monda, presidente dell’associazione Fulop, da anni impegnata in campagne nazionali di prevenzione delle Ica e nella lotta all’antibiotico -resistenza. «Stiamo lavorando con il governo – ha aggiunto Di Monda – nell’ambito del tavolo tecnico per la legge su Ica e Amr, con l’obiettivo di introdurre provvedimenti mirati per la riduzione delle infezioni ospedaliere. A partire dalla sensibilizzazione dei manager su questi temi e dall’avvio di campagne di informazione e prevenzione per il personale sanitario e per l’utenza delle strutture mediche e ospedaliere. In gioco c’è la salvaguardia del sistema sanitario nazionale, fiore all’occhiello del nostro Paese, e di migliaia di vite umane che potrebbero essere salvate osservando semplicemente alcune prassi di buon senso».
«Abbiamo iniziato a raccogliere i primi dati relativi ai risarcimenti pagati dalle Aziende sanitarie e ospedaliere per i casi di malpractice e ci siamo resi subito conto delle enormi difformità, della poca trasparenza in alcuni casi e delle incongruenze che rendono molto complesso avere un quadro realistico a livello nazionale sulla spesa sanitaria legata a questi fenomeni» ha sottolineato Eleonora Coletta, presidente Osm che cita ad esempio il dato ricevuto dall’Agenzia di tutela della salute di Bergamo dal quale emerge «che negli ultimi cinque anni non ci sarebbero sinistri liquidati. Di contro ci sono i dati estrapolati dalla Banca del contenzioso dell’Emilia Romagna dai quali emergono risarcimenti per milioni di euro. Per questo – ha concluso Coletta – l’Osservatorio si è strutturato con figure tecniche di alto livello che ci aiuteranno nello studio dei bilanci, nell’individuazione delle criticità e nella proposta di soluzioni per ridurre la spesa sanitaria».
Rimani aggiornato su www.vocesanità.it resistenza microbica